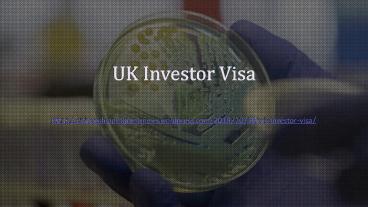

UK Investor Visa PowerPoint PPT Presentation
Title: UK Investor Visa
1
UK Investor Visa
- https//citizenshipprogramsnews.wordpress.com/2019
/10/30/uk-investor-visa/
2
- Looking for a diverse, prosperous and perfectly
located place to call home? Look no further than
the U.K., an economic and cultural hub boasting
one of the best and most sought-after standards
of living in the world.
3
- Golden Visas are designed to attract business
people by providing citizenship to them. - The U.K. Investor Program is a three-tiered
system that enables and grants residency so to
their investor. To qualify for the program,
applicants must meet the below criteria
4
INVESTMENT OPTIONS
- Applicants must invest 75 percent of the
specified investment amount in the U.K. Remaining
25 must be invested by purchasing assets or
depositing funds in the U.K. - The higher the investment, the faster the
applicant will obtain their stay in the UK.
5
TIER 1 UK INVESTOR VISA
- Tier 1 investor visa holders can work and study
in the UK, by investing in the business, and can
also apply to settle after a set period of time
which depends on how much they have invested in
the UK.
6
UK INNOVATOR VISA AND START UP VISA
- The UK government has closed the Tier 1 UK
Entrepreneur Visa in March 2019 and it is
replaced with UK Innovator Visa and Startup Visa.
These visas are designed for entrepreneurs who
are willing to build innovative businesses. The
applicant can have a genuine and original
business plan.
7
Innovator Category
- The UK Innovator category is designed for more
experienced business people. Which requires a
Minimum investment of 50,000. Applicants can
reside for three years, in the UK with their
families.
8
This article is originally appeared on
- https//citizenshipprogramsnews.wordpress.com/2019
/10/30/uk-investor-visa/
PowerShow.com is a leading presentation sharing website. It has millions of presentations already uploaded and available with 1,000s more being uploaded by its users every day. Whatever your area of interest, here you’ll be able to find and view presentations you’ll love and possibly download. And, best of all, it is completely free and easy to use.
You might even have a presentation you’d like to share with others. If so, just upload it to PowerShow.com. We’ll convert it to an HTML5 slideshow that includes all the media types you’ve already added: audio, video, music, pictures, animations and transition effects. Then you can share it with your target audience as well as PowerShow.com’s millions of monthly visitors. And, again, it’s all free.
About the Developers
PowerShow.com is brought to you by CrystalGraphics, the award-winning developer and market-leading publisher of rich-media enhancement products for presentations. Our product offerings include millions of PowerPoint templates, diagrams, animated 3D characters and more.